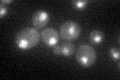
YGL194C
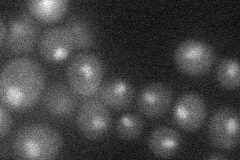
YGL194C
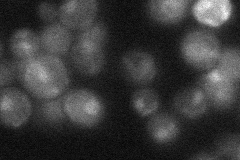
YGL194C
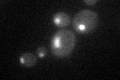
YGL194C

View description
Histone deacetylase required for gene activation via specific deacetylation of lysines in H3 and H4 histone tails; subunit of the Set3 complex, a meiotic-specific repressor of sporulation specific genes that contains deacetylase activity
Localization:
Intensity:
Fold change:
Significance:
-
C’ GFP library in SD
nucleus34.87 -
N' NOP1pr-GFP in SD

cytosol,nucleus43.0033 -
N' TEF2pr-mCherry in SD
nucleus16.0426 -
N' NATIVEpr-GFP in SD
nucleus21.1083 -
N' TEF2pr-VC and Cyto-VN in SD

#N/A0 -
C’ GFP library in SD+DTT

nucleus36.261.03No -
C’ GFP library in SD+H2O2

nucleus37.61.07No -
C’ GFP library in Starvation Media
nucleus36.571.04No -
C’ GFP library on the background of Pup2-DaMP

nucleus -
C’ GFP library on the background of CCT mutant

nucleus37.96251.08841No
